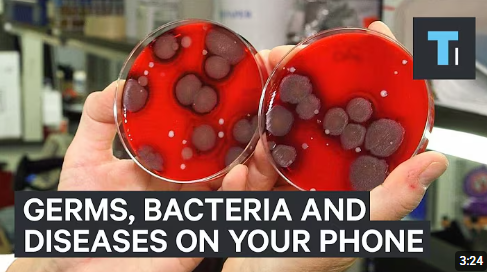
手機細菌量達馬桶座10倍!亂用酒精抹Mon如「自毀屏幕」Apple教2招正確清潔

你知道每天拿在手上的手機,竟然可能比馬桶座還要骯髒10倍,更可怕的是,許多民眾為了消毒,竟然隨手拿起酒精狂噴,卻不知這一招可能加速手機螢幕「自我毀滅」。究竟該怎麼安全又有效地清潔手機?現在就揭開手機清潔的真相與正確做法!
您每天不離身的手機,其細菌量可能比馬桶座還要高出10倍以上!更糟的是,許多人習慣用酒精消毒,卻可能因此破壞手機螢幕的保護塗層。究竟該如何安全有效地清潔您的iPhone?Apple官方已給出明確指引。
Q&A:手機衞生大解密
面對驚人的「細菌溫床」,許多人會直覺拿起酒精消毒,但您知道嗎?這個看似有效的舉動,其實正在悄悄破壞手機螢幕的保護層,加速它「自我毀滅」。究竟為什麼我們習慣的清潔方式反而會造成傷害?以下將透過Q&A,帶您深入了解這背後的科學原由:
Q1:手機上的細菌多誇張?
A:根據《Time Magazine》,手機平均每平方吋約超過17,000個細菌單位,遠高於馬桶座(約1,201個),髒汙程度相當驚人。
Q2:手機為什麼這麼髒?
A:手機幾乎24小時不離身,不斷沾染來自手掌、臉部、口水、灰塵、皮屑和油脂。加上多數人清潔意識不足,使其成為名符其實的「細菌超級溫床」。
Q3:為什麼酒精會傷手機?
A:手機螢幕表面覆蓋有極重要的「疏油塗層」,用來防指紋和油污。酒精屬於強溶劑,長期使用會溶解並剝離這層保護膜,導致螢幕更容易沾指紋,甚至出現刮傷和霧化,加速螢幕老化。
Apple親授:正確清潔手機的2大方法
既然我們了解了酒精清潔對手機螢幕的傷害,那麼究竟該如何安全地為您的愛機「消毒」?別擔心,Apple 官方早已給出最權威且有效的指引,強調必須安全、溫和、有效。以下將揭示 Apple 親授的2大方法,教您如何正確選擇工具、執行步驟,讓您的手機乾淨又不傷機:
1. 選擇合適的清潔劑與作用範圍
建議使用: 可使用 70%異丙醇(Isopropyl Alcohol,IPA) 濕巾,或 Clorox(氯雷士)等品牌生產的抗菌濕巾。
使用方式: 僅可輕輕擦拭螢幕與機身外殼。
關鍵警示: 切勿讓任何液體滲入手機開口,如接口或揚聲器孔。
絕對避免: 避免使用工業酒精、高濃度乙醇、漂白水、氨水、玻璃清潔劑,或任何含有過氧化氫的產品,這些化學物質會嚴重損害手機的保護塗層。
2. 採用柔軟無絨布擦拭
建議工具: 微纖維布(Microfiber Cloth)(如眼鏡布)是清潔手機的最佳選擇。
乾擦去污: 清潔時,不需用水或清潔劑,只要乾擦即可去除大部分污漬。
濕擦技巧:若必須濕擦,請將極少量的水噴在布上,不可直接將液體噴灑在手機上。
禁止使用的工具與清潔注意事項
為確保清潔過程不損壞您的手機,請嚴格遵守以下工具選擇與操作的限制:
1. 禁用工具與材質
禁止使用:粗糙的布料、毛巾、紙巾或類似物品、金屬刷,以免在螢幕或機身上留下刮痕。
禁止使用氣體:請勿使用氣霧劑 或 壓縮空氣(此為先前資訊,在此補充強調)。
2. 禁用清潔劑與化學藥品
禁止使用:漂白水或研磨劑。
禁止使用其他強烈化學品:請勿使用氨水、玻璃清潔劑或含有過氧化氫的產品。
3. 清潔操作警示
斷電處理: 清潔前,請務必拔掉所有外部電源、設備和線材。
清潔頻率建議:專家怎麼說?
為了維持手機衛生,重症醫療專業醫生黃軒 Dr. Ooi Hean建議應將清潔習慣融入日常生活中:
基礎頻率:手機應每天至少清潔一次。
重點清潔時機:特別是在外出回家、使用大眾交通工具後,或上完廁所後,應立即進行清潔。
高頻建議:若您膚質容易出油,或經常在公共場所長時間使用手機,建議將清潔頻率提高到1天2次以上。
資料及圖片來源:Apple官方網站、Youtube@Daniel About Tech、Facebook@黃軒醫師 Dr. Ooi Hean、unsplash、《Time Magazine》
iPhone密碼錯太多停用?Apple教 2 招「解鎖自救法」免用電腦救手機資料
iPhone密碼輸錯太多不只是被鎖這麼簡單,Apple為了保護用戶資料安全,內建了密碼錯誤的鎖定機制,一旦輸入次數過多,不僅等待時間會越來越長,還可能導致手機被「完全停用」。但別擔心,官方其實提供了 2 種方式幫你「解鎖重生」。這兩種方法都會清除裝置上的所有資料和設定,不過,其中一種方法能讓您在重置後,透過 iCloud 或電腦備份將資料還原回手機,讓您最大程度地找回重要檔案!